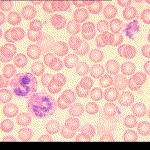
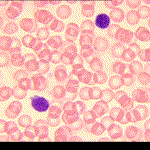
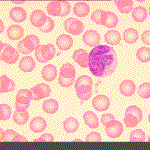

TEJIDOS ANIMALES
1) adiposo 2)adiposo 3) cartilaginoso 4) cartilaginoso

1)tejido óseo compacto 2) tejido conjuntivo denso 3)conjuntivo laxo 4)epitelio ciliado 4) sangre con granulocitos,linfocitos ,macrófago y plaqueta




7) muscular liso 8) muscular estriado 9)muscular cardiaco 10)axón-músculo estriado


e) tejido nervioso b)neurona